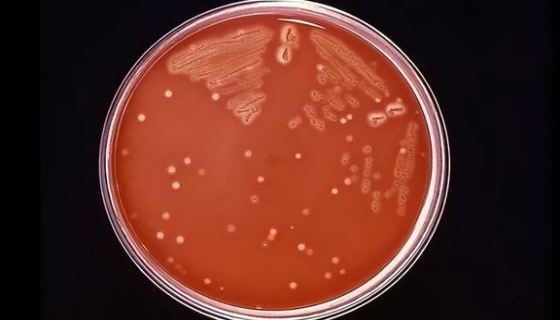
嗜肉考克氏菌的特点与优势及培养与保存！

TEC人胸腺上皮细胞的培养操作规程及注意事项!
TEC人胸腺上皮细胞仅用于科学研究或者工业应用等非医疗目的不...

棒状杆菌属的培养特性与致病物质及防治原则!
棒状杆菌属细菌为革兰阳性直或微弯曲杆菌,菌体不分枝、两边不平...

人类鳞状上皮舌癌细胞的处理方法与培养步骤!
SCC-9人类鳞状上皮舌癌细胞接收后的处理方法与培养步骤及注...
嗜肉考克氏菌的特点与优势及培养与保存!
嗜肉考克氏菌是Kocuria属的微生物,原产地为中国。革兰氏...

粪产碱杆菌 国家标准菌种 CMCC(B)40001
粪产碱杆菌,外型为杆、短杆或球状,直径为0.5~1.0mm,...

ATCC 17749 溶藻弧菌的培养方法与实验内容!
溶藻弧菌属弧菌科,弧菌属,又称解藻阮酸弧菌、解藻酸弧菌或解藻...

ATCC 51837 玫瑰色新鞘氨醇菌 百欧博伟生物
玫瑰色新鞘氨醇菌是Novosphingobium属的微生物,...

长双歧杆菌的培养方法与实验内容及注意事项!
长双歧杆菌(BL),是益生菌的一种,属于双歧杆菌,是对人体有...

NCI-H82人小细胞肺癌细胞收货处理及培养步骤!
人小细胞肺癌细胞NCI-H82,在生化和形态学上是SCLC的...